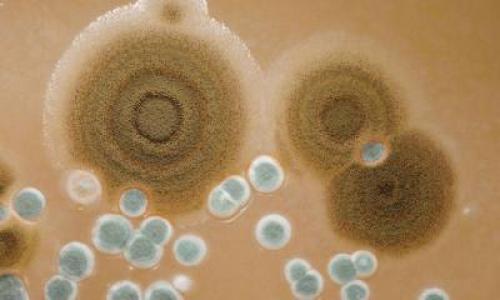
Средство от плесени своими руками. Плесень

Как вывести грибок на стене в квартире. Народные рецепты для применения в домашних условиях
- Как вывести грибок на стене в квартире. Народные рецепты для применения в домашних условиях
- Средство от плесени своими руками. Плесень
- Как избавиться от плесени на стенах в частном доме. 10 лучших средств от плесени и грибка в 2023 году
- Как убрать плесень со стен народными средствами. Чем обработать стены от грибка и плесени?
- Как вывести плесень из организма. Кандидоз кишечника: почему развивается болезнь?
- Чем обработать стены от плесени в домашних условиях. Борьба с плесенью
Как вывести грибок на стене в квартире. Народные рецепты для применения в домашних условиях
 Как удалить черную плесень со стен в комнатах?
Как удалить черную плесень со стен в комнатах?
Если проблема возникла – начать немедленную борьбу можно с подручных средств, имеющихся в каждом доме.
Народные средства имеют ряд преимуществ:
- Эффективность . Особенно на начальных этапах появления плесени.
- Дешевизна . Стоимость каждого средства находится в пределах 100 рублей.
- Есть в каждом доме . У каждой хозяйки найдется хоть одно из перечисленных средств ниже.
Белизна
Концентрат (в неразбавленном виде) нанести на пораженную плесенью поверхность любым удобным способом – губка, щетка. Оставить состав до полного высыхания. Если одной обработки недостаточно — повторить .
Уделить пристальное внимание особо загрязненным участкам. Зайти белизной на незатронутые части для предотвращения распространения.
Обязательно использование защитных прорезиненных перчаток, респиратора . Помещение должно хорошо проветриваться, поскольку пары хлора опасны для здоровья. Способ подходит для начальной стадии заражения.
Как избавиться от плесени на стене при помощи белизны:
Сода и стиральный порошок
На один стакан кипятка (в пропорции 1:2) разводят соду и стиральный порошок . Готовой горячей смесью обрабатывают зараженную поверхность, используя щетку.
Следует оставить до полного высыхания. Способ хорошо зарекомендовал себя в борьбе с плесенью на стыках кафеля, плинтуса. Такой состав рекомендован при заражениях спорами грибка на начальных этапах.
Уксус
Нанести в неразбавленном виде при помощи мягкой щетки, губки. Оставить до полного высыхания.
Если проблема не решена при первом нанесении, обработку повторить до полного исчезновения плесени со стены. Обязательно использовать средства защиты.
Метод подходит для обработки:
- стен,
- камня,
- кафеля.
Перекись водорода
Как убрать в домашних условиях с помощью перекиси?
- Зачистить жесткой щеткой, мочалкой место поражения.
- Оставить на 15-20 мин. для воздействия.
- Далее, развести с 9% уксусной кислотой в соотношении 1:1 и повторить обработку нужного участка.
- Ждать до полного высыхания.
 Распылить флакон в неразведенном виде на стену.
Распылить флакон в неразведенном виде на стену.Способ удобен тем, что не требует смывания, не оставляет следов . Применять только на твердых поверхностях.
Масло чайного дерева
Обработка проводится с помощью распылителя. Пропорция состава – в 1 л. теплой воды развести 25 мл. масла чайного дерева.
При незначительных поражениях допустимо точечное нанесение в неразбавленном виде при помощи ватной палочки, кисти.
Чайное дерево борется на начальных стадиях заражения. Метод требует смывания водой, поскольку способен окрасить поверхность.
После выведения, участок, где была плесень нужно обработать любым химическим составом от черной плесени, чтобы грибок не вернулся на это место.
Бура
 Приготовить состав из 1 части буры (200гр.) и 4 л. воды . Нанести на предварительно зачищенную поверхность.
Приготовить состав из 1 части буры (200гр.) и 4 л. воды . Нанести на предварительно зачищенную поверхность.
Жесткой щеткой втереть смесь в стену. Обработанный участок промокнуть насухо тканью. Оставить до полного просыхания.
Если плесень не исчезла — процедуру повторить. Способ подходит для закрытых и плохо вентилируемых помещений . Использование перчаток – обязательно.
Медный купорос
В борьбе с домашней черной плесенью применяют и медный купорос. Препарат следует нанести в концентрированном виде на стену при помощи губки или мягкой щетки. Оставить до полного высыхания. Это агрессивное средство, зачастую повторное нанесение не требуется .
Лучше этот метод не использовать для помещений с ремонтом, поскольку купорос оставляет несмываемые следы на очищаемой поверхности.
Средство от плесени своими руками. Плесень
Появление в квартире плесени не только малоприятное зрелище, но еще и опасное для здоровья человека явление. Особо опасной является черная плесень .
Появление в квартире плесени не только малоприятное зрелище, но еще и опасное для здоровья человека явление. Особо опасной является черная плесень .
Причина появления одна — сырость. Этот грибок распространяет в помещении споры, которые, распространяясь по воздуху, провоцируют различные заболевания дыхательной системы.
Как убрать плесень? Избавиться от плесени непросто, но все же возможно и своими руками, без привлечения специалистов.
Народные методы борьбы в домашних условиях
Народные рецепты предполагают использование средств, которые есть у каждой хозяйки.
Как убрать с помощью буры?
 Являясь природным антисептиком, бура уничтожает любые болезнетворные микроорганизмы, не исключая плесень.
Являясь природным антисептиком, бура уничтожает любые болезнетворные микроорганизмы, не исключая плесень.
Для приготовления состава нужно:
- 2,5 л. воды смешать с 1 стаканом буры;
- полученный состав наносится на пораженные места жесткой щеткой;
- нанесенное средство не смывается.
Уксус
Даже если воспользоваться концентрированной уксусной кислотой, избавиться от всех разновидностей плесени вряд ли удастся. Преимущество этого средства заключается в его натуральности и нетоксичности. Он совершенно безвреден.
Для нанесения на пораженные зоны используется распылитель или губка . Разведение с водой не требуется.
После нанесения уксус рекомендуется оставить на час, потом ополоснуть водичкой и оставить высыхать. Комнаты в этот период должны проветриваться, так как уксус имеет достаточно едкий запах.
Уксус можно использовать для профилактики , обрабатывая им предполагаемые зоны поражения раз в 15 дней.
Сода
 Безопасная и безвредная сода — враг плесени. Если участок сильно поражен, то ее можно использовать вместе с уксусом.
Безопасная и безвредная сода — враг плесени. Если участок сильно поражен, то ее можно использовать вместе с уксусом.
1 столовая ложка соды насыпается в 250 мл. воды, тщательно размешивается и полученный состав переливается в пульверизатор.
Средство распыляется на пораженные зоны и оставляется на какое-то время. Затем жесткой губкой или щеткой эти области очищаются и ополаскиваются водой.
После этого снова наносится содовый раствор, но теперь он уже оставляется до тех пор, пока полностью не высохнет. Можно соду положить на влажную ткань и этим оттирать плесень.
Перекись водорода
Нехитрый состав оказывает антибактериальное и противогрибковое воздействие и превосходно справляется с плесенью. Главное преимущество – безвредность.
Удаляет грибковые поражения с любых поверхностей:
- кафеля,
- мебели,
- санфаянса.
Перед применением перекиси следует провести тест, чтобы убедиться, что на обрабатываемой поверхности не останется пятен и разводов.
Для получения состава 3%-ую перекись распыляют на заплесневелые места и оставляют на четверть часа. После этого при помощи щетки удаляется грязь и место поражения промывается водой. Для усиления эффекта перекись смешивается с уксусом.
Нашатырный спирт
 Средство токсично, но обладает отличными фунгицидными свойствами.
Средство токсично, но обладает отличными фунгицидными свойствами.
Разведенным с водой в пропорции 1:1 составом обрабатываются пораженные зоны. Через час эти участки промываются водой.
Нельзя нашатырный спирт смешивать с отбеливателями , так как в результате выделяется токсичный газ.
Мыло
Мыло не способно полностью решить проблему грибка, поэтому после его использования участок обрабатывается любым антисептиком.
Применять просто:
- Намыленной хозяйственным мылом губкой обрабатываются зараженные участки.
- Через некоторое время пену следует смыть.
Отбеливатель
В основе любого отбеливателя находится гипохлорид натрия , который и выступает главным врагом плесени. Одного раза достаточно для избавления от всей грибковой колонии.
Отбеливатель разводится с водой из расчета 1:10 и наносится на заплесневелые зоны пульверизатором. Состав не смывается!
Масло чайного дерева
 Эффективен состав на основе масла чайного дерева. Если его не смывать, то у грибка нет никаких шансов вернуться повторно.
Эффективен состав на основе масла чайного дерева. Если его не смывать, то у грибка нет никаких шансов вернуться повторно.
Секрет средства в особых растительных компонентах, губительных для микробов и грибков.
Для приготовления состава 1 чайная ложка средства разводится в стакане воды . Этот состав распыляется по всему участку с грибком.
Не стоит пугаться ярко выраженного запаха масла чайного дерева. Через определенное время он выветрится.
Марганцовка
Губительна для грибка обычная марганцовка . Для обработки поверхности:
- Готовится раствор из 1 литра воды и 1 чайной ложки перманганата калия.
Как избавиться от плесени на стенах в частном доме. 10 лучших средств от плесени и грибка в 2023 году
В нашей стране, где влажность воздуха достигает высоких значений, а плесень и грибок появляются на стенах, деревянных поверхностях и в ванной комнате являются распространенной проблемой. Приходится искать варианты, чтобы избавиться от этой проблемы
Лучшие средства от грибка и плесени. Фото: shutterstock.com
На рынке сейчас существует множество средств, которые помогут избавиться от этих неприятных явлений. В зависимости от формы выпуска все растворы для борьбы с плесенью и грибка подразделяются на следующие категории:
| Тип средства | Описание |
| Спреи | Нанесение облегчается наличием пульверизатора. Пенная текстура — один из аргументов при покупке; |
| Жидкости | Можно наносить губкой или щеткой. Применяются в качестве концентрата или смешиваются с водой. Поверхности требуют предварительной подготовки. |
В большинстве средств, представленных сейчас на рынке, в качестве основного компонента используется хлор. Но есть и другие, такие, при которых оптимальный сбалансированный состав позволяет проводить уборку и профилактику без вреда для здоровья.
В данной статье собраны лучшие варианты средств от плесени и грибка по мнению редакции проекта «Выбор экспертов». Материал носит рекомендательный характер и не является руководством к покупке и иным действиям.
Выбор редакции
Рейтинг составлен на основе мнения редакции КП. Рекомендации и дополнения по рейтингу вы можете отправить на почту expert@kp.ru . Для обсуждения вопросов рекламного сотрудничества звоните по телефону +7 (495) 637-65-16 (по будням с 9:00 до 18:00).
Pro-Brite Alfa-19
Pro-Brite Alfa-19. Фото: yandex.market.ru
Средство для борьбы с плесенью Alfa-19 продается в пластиковом флаконе объемом один литр. Состав на основе кислот, воды и ПАВ предназначен для устранения ржавчины, остатков строительных материалов, высолов (белого налета) на кладке из кирпича, плесени и прочих загрязнений. Можно применять на различных поверхностях: полу, стенах и фасадах. Можно даже несколькими способами: при разведении с водой или нанесением распылителем.
Покупатели утверждают, что концентрированная рецептура прекрасно удаляет различные типы загрязнений и плесени с первого раза. Формула на основе едких веществ требует аккуратного обращения при нанесении. Необходимо подготовиться и защитить руки и органы дыхания.
Основные характеристики
Плюсы и минусы
Устраняет плесень с первого раза, подходит для разных поверхностей
Требует осторожного обращения
Показать еще
Рейтинг топ-3 лучших средств от плесени и грибка для стен
HG
HG. Фото: yandex.market.ru
Средство для удаления грибка и плесени быстро справится с опасными налетами, продезинфицирует поверхности и обеспечит идеальную чистоту. Использовать можно на стенах и поверхностях из любого материала: кафель, пластик, дерево, резина, силикон и другие. Средство не требует интенсивной чистки, благодаря чему не наносятся повреждения поверхностям. Производитель гарантирует эффективность даже при применении на влажных местах.
Спрей не только убивает микроорганизмы, но дезинфицирует и отбеливает поверхность. Средство не менее эффективно на швах между плиткой, штукатурке, резиновых и силиконовых уплотнителях. Активное вещество — хлор, поэтому при применении всегда сохраняется стойкий запах.
Основные характеристики
Плюсы и минусы
Не повреждает поверхность, подходит для разных поверхностей
Стойкий запах
Показать еще
Как избавиться от плесени в квартире
Узнайте, как избавиться от плесени раз и навсегдаDALI
DALI. Фото: yandex.market.ru
Универсальное средство от грибка и плесени для поверхностей из дерева, бетона, кирпича и гипсокартона. Жидкость легко проникает даже под слой штукатурки, а значит, нет необходимости в предварительной подготовке до начала работ. DALI не содержит хлора, быстро впитывается и не портит внешний вид стен. Следует соблюдать технику безопасности, использовать респиратор, защитные перчатки.
Температура при обработке должна быть не ниже пяти градусов тепла. В случае если поверхность сильно заражена, необходимо выполнить подготовку. Очистить местность механическим способом, тщательно промыть водой и полностью высушить. Нельзя использовать средство на влажной поверхности. Остатки загрязнений после обработки убрать щеткой по истечении двух суток.
Как убрать плесень со стен народными средствами. Чем обработать стены от грибка и плесени?
Вы уже знаете, что плесень на стене в доме опасна, и нужно немедленно с ней бороться. Но стоит делать это правильно. Не спешите сразу счищать пятна со стен, так свежие споры разлетятся по помещению и осядут на непораженные предметы. Лучше до начала процедуры обработать стены специальными дезинфицирующими средствами и только потом соскребать плесень жестким скребком или щеткой. После просушите стену и проветрите помещение, а затем приступайте к основной обработке. Хорошо справятся с задачей специальные антибактериальные препараты (Belinka, Well Done, Remmers Schimmel-Stop и др.), которые можно приобрести в магазине.
Для усиления эффекта обработку рекомендуется повторить через неделю.
Как убрать плесень со стены народными средствами? Все зависит от степени поражения поверхности. Сильные повреждения говорят о том, что грибок глубоко въелся в поверхность, поэтому уничтожать его придется химическими препаратами. Если же пятна еще небольшие, на помощь придут более безопасные для здоровья средства от плесени.
| Средство от плесени | Для каких поверхностей подходит | Способ применения |
| Хлорсодержащий отбеливатель | Плитка, стекло и другие непористые поверхности | Разбавьте в соотношении 1:10, распылите на поверхность или нанесите с помощью губки |
| Перекись водорода | Любые поверхности, но перед применением стоит проверить на небольшом участке, т.к. перекись обладает обесцвечивающей способностью | Распылите 3%-ный раствор на поверхность или обработайте им стены с помощью губки |
| Бура (натриевая соль борной кислоты) | Кафель, стекло, дерево | Разбавьте 1 стакан в 2,5 л воды, нанесите на стены жесткой щеткой. Смывать не нужно. |
| Пищевая сода | Любые поверхности | Растворите 1 ч.л. в стакане воды и обрызгайте пораженные места либо протрите губкой. Через час промойте стену чистой водой. |
| Столовый уксус | Любые поверхности | Распылите на стену, затем протрите ее губкой, смоченной в уксусе. Через час промойте поверхность чистой водой. |
Если плесень появилась на обоях , скорее всего стены под ними также поражены. Но это не значит, что нужно срочно начинать грандиозный ремонт. Сначала оцените степень поражения. Если пятен и разводов мало и они локализованы в одном месте, можно попробовать остановить распространение грибка. Для этого хорошенько проветрите помещение, прогрейте с помощью печи или камина. Затем уберите плесневый налет содовым раствором (1 ч.л. на 1 стакан теплой воды). Используйте мягкую губку, чтобы не повредить обои. После дайте стене высохнуть. Существуют и другие способы, как удалить плесень с обоев: столовый уксус и перекись водорода. Залейте их в распылитель или нанесите на губку, затем обработайте обои. После просушите стену и хорошо проветрите помещение. Только помните, что перекись может обесцветить обрабатываемую поверхность.
В случае сильного поражения стены придется убрать обои, опрыскать плесневые участки и зачистить стену до штукатурки. Затем проведите обработку, о которой мы упоминали выше.
Как вывести плесень из организма. Кандидоз кишечника: почему развивается болезнь?

Кишечный кандидоз представляет собой инфекционное заболевание грибковой природы, поражающее слизистые оболочки желудочно-кишечного тракта. Эта патология — одна из важнейших проблем современной гастроэнтерологии: довольно сложно вовремя определить природу недуга. Это связано с повсеместной распространенностью возбудителя — грибка рода Candida, который также является компонентом микрофлоры организма совершенно здорового человека (около 80% населения — бессимптомные носители).
Медики выделяют две основные формы грибковой инфекции: инвазивную и неинвазивную. Чаще всего встречается первая форма недуга: она развивается на фоне дисбактериоза и перенесенного инфекционного заболевания, поражающего желудочно-кишечный так. Грибки Candida начинают активно размножаться в просвете кишечника, но не проникают в слизистую оболочку. При этом выделяется большое количество токсичных продуктов обмена, которые оказывают раздражающее воздействие на кишечник. Они провоцируют дальнейшее прогрессирование дисбактериоза, а также способствуют формированию аллергических реакций.
Инвазивный кандидоз развивается по совершенно другому механизму. На фоне ослабленного иммунитета грибки плотно прикрепляются к кишечному эпителию, после чего проникают глубоко в его толщу. Нередко происходит распространение Candida по системному кровотоку, в результате чего поражаются другие органы и ткани (печень, поджелудочная железа). Вероятность развития недуга увеличивают следующие факторы:
- беременность;
- пожилой или молодой возраст;
- онкологические заболевания;
- курс антибактериальной, кортикостероидной или лучевой терапии;
- эндокринные патологии;
- врожденные и приобретенные иммунодефицитные состояния.
Чем обработать стены от плесени в домашних условиях. Борьба с плесенью
Как вывести грибок на стенах, используя средства, доступные каждому? Существует множество народных способов, позволяющих быстро и надежно решить проблему. Рассмотрим основные из них:
- Бура. Отличный метод выводить грибок, полностью безопасный для здоровья человека. пропорции для раствора: 150 г разбавить литром воды, нанести средство при помощи щетки. Плесень со стен будет удалена, а бура выполнит также и профилактическую функцию: если поверхность не протирать, то растров будет препятствовать повторному образованию грибка.
- Нашатырный спирт. Прекрасно подойдет для того, чтобы убить грибок на кафеле, плитке, стекле. Следует приготовить водный раствор, смешав равные порции спирта и воды, затем нанести средство на поверхность, используя пульверизатор. Важно помнить, что спирт обладает резким неприятным запахом, побочным эффектом может стать головная боль, тошнота, характерные ощущения в горле, поэтому при его использовании очень важно обеспечить в помещении вентиляцию. Для защиты дыхательных путей обязательно использовать респиратор.
- Отбеливатель. Идеален для уничтожения плесени с непористых поверхностей (кафеля, плитки). Однако для деревянных пористых и гипсокартонных стен не рекомендуется: микроорганизмы будут удалены лишь с поверхности, поэтому спустя некоторое время появятся повторно.
Пропорции средства: на 1 литр воды - 100 г отбеливателя (можно использовать обыкновенную белизну). Состав наносится на стену губкой или пульверизатором (при использовании губки обязательно надеть перчатки). Средство очень ядовито, поэтому использовать можно лишь в том случае, если помещение недоступно детям. Так, на кухне этот метод не подойдет.
Важно! Нашатырный спирт и отбеливатель нельзя использовать одновременно!
- Сода. Раствор приготовить несложно: пару ложек соды развести в воде, затем обработать поверхность, дать высохнуть. Наиболее пораженные участки стены рекомендуется почистить жесткой губкой. Если после обработки соды поверхность потереть уксусом, то произойдет губительная для плесени химическая реакция.
- Медный купорос. Среди плюсов этого средства возможно назвать простоту в использовании, высокую эффективность и бюджетную стоимость. Он представляет собой ярко-голубые гранулы сульфата меди. 100 г таких гранул необходимо растворить в теплой воде (10 литров) в емкости из металла. Получается 10% раствор медного купороса.
Стену, зараженную плесенью, следует предварительно очистить водой с мылом, а потом нанести тщательно перемешанный раствор. Для этого можно использовать губку или пульверизатор. Медный купорос может использоваться в качестве средства профилактики: им следует обрабатывать стены, находящиеся в зоне риска. Однако важно помнить: обработка стен медным купоросом оставит после себя голубоватый отпечаток.
- Фурацилин. Довольно простое в применении и эффективное средство: в стакане воды растворяется 10 предварительно измельченных пилюль, полученным препаратом обрабатывается поверхность. Средство хорошо еще и тем, что полностью безопасно для людей.